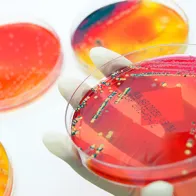
Antimicrobial resistance. © Istockphoto

Campaigns in Europe
A number of initiatives are taking place across Europe to spread the messages on the risks associated with inappropriate use of antibiotics and how to take antibiotics responsibly.
Belgium

Belgian Antibiotic Policy Coordination Committee (BAPCOC)

Belgian Antibiotic Policy Coordination Committee (BAPCOC)

Belgian Antibiotic Policy Coordination Committee (BAPCOC)

Le service public fédéral (SPF) Santé publique, Sécurité de la Chaîne alimentaire et Environnement

De Federale overheidsdienst (FOD) Volksgezondheid, Veiligheid van de Voedselketen en Leefmilieu

Der föderale öffentliche Dienst (FÖD) Volksgesundheit, Sicherheit der Nahrungsmittelkette und Umwelt

The Federal Public Service (FPS) Health, Food Chain Safety and Environment
Croatia

Hrvatsko Društvo za Kliničku Mikrobiologiju (HDKM)
Czechia

Státní Zdravotní Ústav (SZÚ)
Denmark

Antibiotikaellerej.dk er del af en national kampagne om hensigtsmæssig brug af antibiotika
Estonia

Sotsiaalministeerium

Eesti Teadusagentuur
Finland

Terveyden ja Hyvinvoinnin Laitos (THL)
France

Santé Publique France

RéPias (Réseau de Prévention des Infections associées aux Soins)

Santé Publique France
Germany

Bundeszentrale für gesundheitliche Aufklärung (BzgA)

Robert Koch Institut (RKI)
Greece

Κέντρο Ελέγχου & Πρόληψης Νοσημάτων
Hungary

Állami Népegészségügyi és Tisztiorvosi Szolgálatot (ÁNTSZ)
Ireland

AMRIC guidance on IPC and AMR

New Infection Prevention and Control guidelines published by the Irish Department of Health

Health Service Executive (HSE)

Health Service Executive (HSE)

Health Service Executive (HSE)

Health Service Executive (HSE)

Health Service Executive (HSE)

Health Service Executive (HSE)

Health Service Executive (HSE)

Health Service Executive (HSE)

Health Service Executive (HSE)

Health Service Executive (HSE)

Order RESIST publications on IPC and AMR

AMRIC (Antimicrobial Resistance and Infection Control) Training modules and other IPC & AMR resources for healthcare workers.
Italy

Ministero della Salute

Ministero della Salute

Il portale dell'epidemiologia per la sanità pubblica - Istituto Superiore di Sanità (ISS)
Latvia

Antibiotiku lietošana, Slimību profilakses un kontroles centra nolikums
Lithuania

Lietuvos Respublikos sveikatos apsaugos ministerija
Luxembourg

Government of Luxembourg
Netherlands

Antibioticagebruik

Rijksinstituut voor Volksgezondheid en Milieu

Rijksinstituut voor Volksgezondheid en Milieu

SWAB is an initiative of the associations of ID-physicians, Microbiologists and Hospital Pharmacists. It provides guidelines, advice, education and e.g webinars on antibiotic use and antimicrobial resistance and stewardship in the WAAW
Norway
Norwegian Institute of Public Health

Helsedirektoratet

Helsedirektoratet

Norwegian Institute of Public Health
Poland

Narodowy Program Ochrony Antybiotyków
Portugal

Direção-Geral da Saúde
Romania

CNEPSS - Institutul National de Sanatate Publica.
Slovakia

Slovenský Pacient
Slovenia

Nacionalni institut za javno zdravje

Nacionalni inštitut za javno zdravje

Nacionalni inštitut za javno zdravje

Nacionalni inštitut za javno zdravje

Nacionalni inštitut za javno zdravje
Spain

Antibiotic Awareness Day 2023 site

2023 AMR campaign site

Antimicrobial resistance action plan

Mobile game that teaches players about antimicrobial resistance

Platform to check antibiotic consumption in Spain.
Sweden

Folkhalsomyndigheten

